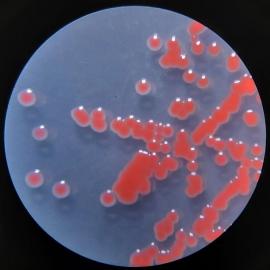
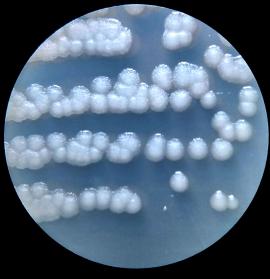
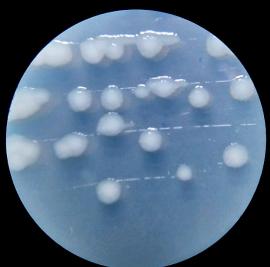
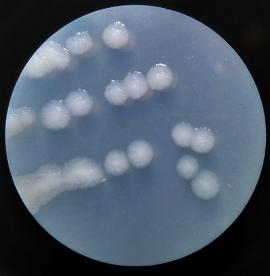
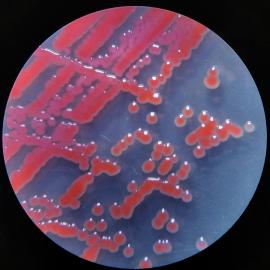

- หน้าแรก
- เกี่ยวกับเรา
-
ทุนทางวัฒนธรรม
- Local Stories and Legends
- History, Culture, Tradition and Ways of Life in Satun UNESCO Global Geopark
- Major Geosites and Geotourism Sites in Satun UNESCO Global Geopark
- General Information on Satun UNESCO Global Geopark
- เรื่องเล่าและตำนานท้องถิ่น
- ประวัติศาสตร์ วัฒนธรรม ประเพณี และวิถีชีวิต
- แหล่งธรณีและแหล่งท่องเที่ยวเชิงธรณีสำคัญของอุทยานธรณีสตูล
- ข้อมูลทั่วไปของอุทยานธรณีโลกสตูล
- เอกสารเผยแพร่
- บุคคล
- สถานที่
- วัตถุทางวัฒนธรรม
- วิถีชีวิต
-
-
- เส้นทางท่องเที่ยว
- ทรัพยากรชีวภาพ
- กิจกรรม
- ติดต่อเรา
- หน้าแรก
- เกี่ยวกับเรา
- ทุนทางวัฒนธรรม
- Local Stories and Legends
- History, Culture, Tradition and Ways of Life in Satun UNESCO Global Geopark
- Major Geosites and Geotourism Sites in Satun UNESCO Global Geopark
- General Information on Satun UNESCO Global Geopark
- เรื่องเล่าและตำนานท้องถิ่น
- ประวัติศาสตร์ วัฒนธรรม ประเพณี และวิถีชีวิต
- แหล่งธรณีและแหล่งท่องเที่ยวเชิงธรณีสำคัญของอุทยานธรณีสตูล
- ข้อมูลทั่วไปของอุทยานธรณีโลกสตูล
- เอกสารเผยแพร่
- บุคคล
- สถานที่
- วัตถุทางวัฒนธรรม
- วิถีชีวิต
- เส้นทางท่องเที่ยว
- ทรัพยากรชีวภาพ
- กิจกรรม
- ติดต่อเรา
- ความหลากหลายทางชีวภาพ